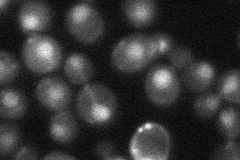
YKR063C
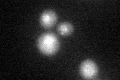
YKR063C
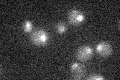
YKR063C

View description
Essential nuclear protein possibly involved in bud formation and morphogenesis; mutants require the SSD1-v allele for viability
Localization:
Intensity:
Fold change:
Significance:
-
C’ GFP library in SD

nucleus20.87 -
N' NOP1pr-GFP in SD

nucleus46.5137 -
N' TEF2pr-mCherry in SD

nucleus9.84528 -
N' NATIVEpr-GFP in SD
nucleus25.7256 -
N' TEF2pr-VC and Cyto-VN in SD

#N/A0 -
C’ GFP library in SD+DTT
nucleus21.711.03No -
C’ GFP library in SD+H2O2

nucleus18.040.86No -
C’ GFP library in Starvation Media
nucleus16.050.76Yes -
C’ GFP library on the background of Pup2-DaMP

nucleus -
C’ GFP library on the background of CCT mutant

nucleus25.84821.23797No
